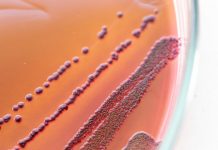
Research: Is it possible? Evolutionary biologists explore the role of history in evolution —

Research: Molecular inhibition gets cells on the move —
To respond to changes in their environment, individual cells, including some of those that compose complex organisms, need to move. This can be...
Research: Predictive model suggests surge in weed —
A new predictive model developed by an ecologist at the University of Massachusetts Amherst and a climate scientist at the University of Washington...
Research: Making wind farms more efficient —
With energy demands rising, researchers at Penn State Behrend and the University of Tabriz, Iran, have completed an algorithm -- or approach --...
Research: A toast to the proteins in dinosaur bones —
Burnt toast and dinosaur bones have a common trait, according to a new, Yale-led study. They both contain chemicals that, under the right...
Research: Biodiversity draws the ecotourism crowd —
Nature -- if you support it, ecotourists will come. Managed wisely, both can win.
The balancing act of protecting and fostering biodiversity with hordes...
Research: Healing kidneys with nanotechnology —
Each year, there are some 13.3 million new cases of acute kidney injury (AKI), a serious affliction. Formerly known as acute renal failure,...
Research: Is it possible? Evolutionary biologists explore the role of history in evolution —
How predictable is evolution? The answer has long been debated by biologists grappling with the extent to which history affects the repeatability of...
Research: Study tracks severe bleaching events on a Pacific coral reef over past century...
As climate change causes ocean temperatures to rise, coral reefs worldwide are experiencing mass bleaching events and die-offs. For many, this is their...
Research: Material could be used to coat windows, save on air-conditioning costs —
To battle the summer heat, office and residential buildings tend to crank up the air conditioning, sending energy bills soaring. Indeed, it's estimated...
Research: Florida monarch butterfly populations have dropped 80 percent since 2005 —
A 37-year survey of monarch populations in North Central Florida shows that caterpillars and butterflies have been declining since 1985 and have dropped...
Top News
Hey ISIS, You Suck: Local Muslims Post Anti-ISIS Billboard
A new billboard on Manchester Road in Missouri reads, "HEY ISIS, YOU SUCK!!! From: #ActualMuslims."
A group of Muslim-Americans have put up a blunt billboard...